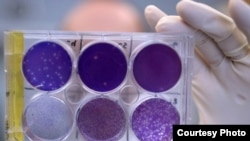
Le chercheurs étudient le virus du Zika à Saint Louis, Missouri.

Cette étude porte sur un sous-groupe de 250 femmes infectées de façon certaine par le Zika. Parmi elles, 24 portaient un foetus ou ont donné naissance à un enfant qui avait un défaut cérébral.
"Le Zika continue à être une menace pour toutes les femmes enceintes à travers les Etats-Unis", a rappelé la Dr Anne Schuchat, directrice par intérim des CDC, soulignant "le retour prochain d'un temps plus chaud et l'approche de la saison des moustiques".
Ce rapport insiste sur l'importance pour les services médicaux de procéder à un dépistage systématique d'une infection par le Zika pour toutes les femmes enceintes potentiellement exposées au virus. Leurs enfants doivent aussi être évalués pour détecter d'éventuelles malformations, ce qui n'est pas toujours le cas.
Selon de précédentes estimations, près de 1.300 femmes enceintes avec des signes d'infection possible par le Zika avaient été dénombrées entre janvier et décembre 2016 dans les 50 Etats américains et tous les territoires d'outre mer, à l'exception de Porto Rico.
Sur les mille grossesses venues à terme à la fin de 2016, plus de 50 nouveaux-nés avaient des malformations congénitales qui pourraient avoir résulté d'une infection par le Zika. Mais ces données n'avaient pas été confirmées de façon certaine par des analyses en laboratoire.
La plupart de ces femmes avaient été infectées en voyageant dans des pays ou territoires américains où la transmission du virus par des moustiques était active.
Les CDC soulignent en outre qu'une infection par ce virus au premier trimestre de la grossesse présente le plus grand risque pour le foetus puisque environ 15% des enfants affectés dans ce cas sont nés avec des malformations congénitales.
Le rapport montre aussi qu'environ un nouveau-né sur trois potentiellement exposé à une infection durant la grossesse n'a pas été testé à la naissance pour de possibles défauts neurologiques. Et seulement un sur quatre a eu un scanner du cerveau.
Avec AFP